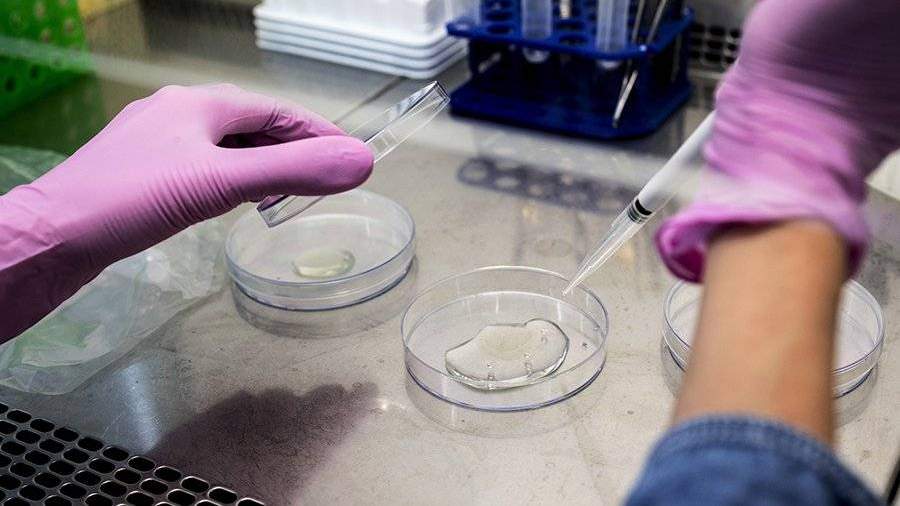

Ученые из РФ и Европы испытают новый метод лечения рака
Ученые из России, Германии и Латвии собираются испытать новый метод лечения рака до конца 2018 года.
Об этом заявили СМИ со ссылкой на пресс-службу Томского госуниверситета (ТГУ).
«Суть принципиально нового подхода к лечению онкозаболеваний… заключается в том, чтобы «научить» клетки в микроокружении опухоли препятствовать ее росту и метастазированию», — цитирует сообщение ТАСС.
Упор нового метода будет сделан на активацию функций макрофагов по препятствию развития новообразований. Эти функции нужно лишь «включить».
Предполагается, что таким ключиком может стать белок SI-CLP, доставляемый в окружение опухоли с помощью обезвреженного вируса.





